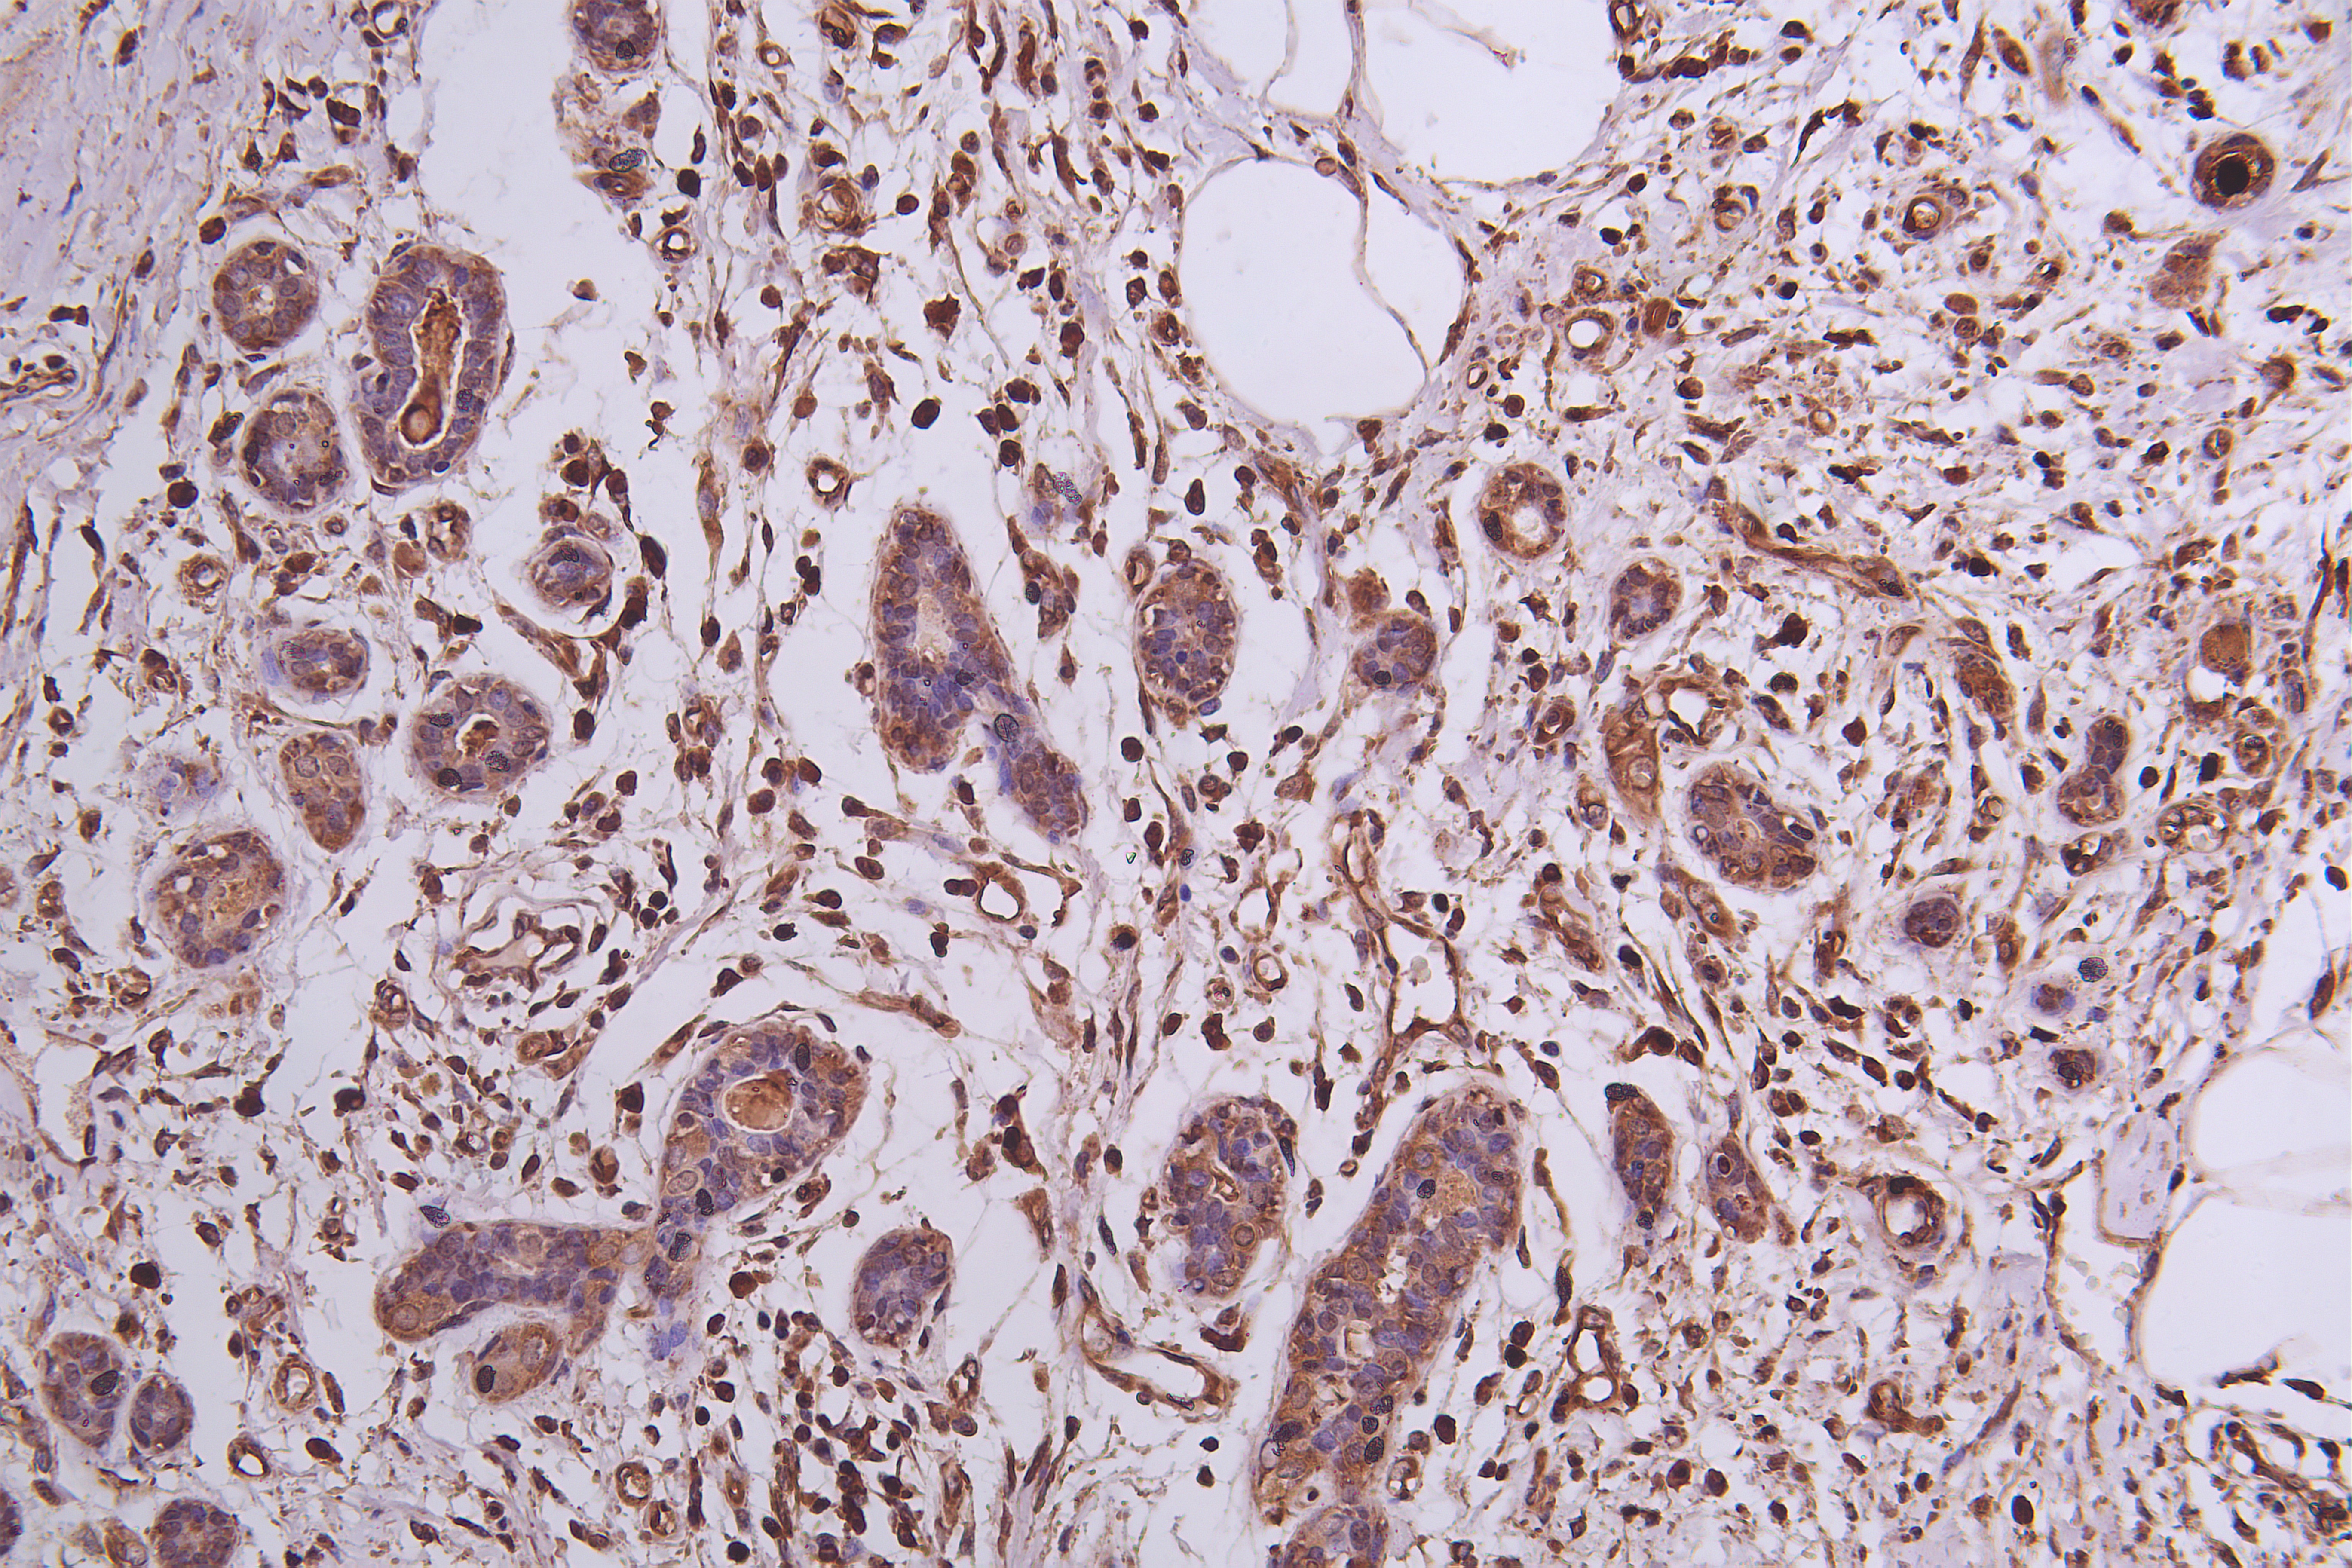

MEST Antibody
-
中文名稱:MEST兔多克隆抗體
-
貨號(hào):CSB-PA704858ESR1HU
-
規(guī)格:¥440
-
圖片:
-
Western blot
All lanes: MEST antibody at 1:500+ Mouse kidney tissue
Secondary
Goat polyclonal to rabbit IgG at 1/10000 dilution
Predicted band size: 39, 38, 34 kDa
Observed band size: 39 kDa -
Western Blot
Positive WB detected in: NTERA-2 whole cell lysate, U87 whole cell lysate, MCF7 whole cell lysate, HT29 whole cell lysate
All lanes: MEST antibody at 1:500
Secondary
Goat polyclonal to rabbit IgG at 1/50000 dilution
Predicted band size: 39, 38, 34 kDa -
Immunohistochemistry of paraffin-embedded human Pancreatic tissue using CSB-PA704858ESR1HU at dilution of 1:50
-
Immunohistochemistry of paraffin-embedded human Placental tissue using CSB-PA704858ESR1HU at dilution of 1:50
-
Immunohistochemistry of paraffin-embedded human Breast cancer using CSB-PA704858ESR1HU at dilution of 1:50
-
Immunofluorescence staining of MCF-7 cells with CSB-PA704858ESR1HU at 1:25, counter-stained with DAPI. The cells were fixed in 4% formaldehyde, permeabilized using 0.2% Triton X-100 and blocked in 10% normal Goat Serum. The cells were then incubated with the antibody overnight at 4°C. The secondary antibody was Alexa Fluor 488-congugated AffiniPure Goat Anti-Rabbit IgG(H+L).
-
-
其他:
產(chǎn)品詳情
-
產(chǎn)品描述:
The recombinant human MEST protein (146-335AA) is used to immunize rabbits to yield the anti-MEST antibody. The resulting MEST polyclonal antibody is purified from rabbit anti-serum through antigen affinity chromatography.
This MEST antibody exists as an unconjugated IgG. And it shows reactivity with human and mouse MEST. MEST has been shown to have both hydrolase and acyltransferase activities, suggesting that it may be involved in lipid metabolism. Additionally, MEST has been implicated in the regulation of glucose metabolism and insulin signaling, as well as in the control of adipogenesis. This anti-MEST antibody has been validated for use in several applications, including ELISA, WB, IHC, and IF.
-
產(chǎn)品名稱:Rabbit anti-Homo sapiens (Human) MEST Polyclonal antibody
-
Uniprot No.:
-
基因名:MEST
-
別名:MEST; PEG1; Mesoderm-specific transcript homolog protein; Paternally-expressed gene 1 protein
-
宿主:Rabbit
-
反應(yīng)種屬:Human, Mouse
-
免疫原:Recombinant Human Mesoderm-specific transcript homolog protein (146-335AA)
-
免疫原種屬:Homo sapiens (Human)
-
標(biāo)記方式:Non-conjugated
-
克隆類型:Polyclonal
-
抗體亞型:IgG
-
純化方式:Antigen Affinity Purified
-
濃度:It differs from different batches. Please contact us to confirm it.
-
保存緩沖液:PBS with 0.02% sodium azide, 50% glycerol, pH7.3.
-
產(chǎn)品提供形式:Liquid
-
應(yīng)用范圍:ELISA, WB, IHC, IF
-
推薦稀釋比:
Application Recommended Dilution WB 1:500-1:2000 IHC 1:20-1:200 IF 1:20-1:100 -
Protocols:
-
儲(chǔ)存條件:Upon receipt, store at -20°C or -80°C. Avoid repeated freeze.
-
貨期:Basically, we can dispatch the products out in 1-3 working days after receiving your orders. Delivery time maybe differs from different purchasing way or location, please kindly consult your local distributors for specific delivery time.
-
用途:For Research Use Only. Not for use in diagnostic or therapeutic procedures.
相關(guān)產(chǎn)品
靶點(diǎn)詳情
-
基因功能參考文獻(xiàn):
- We conclude methylation changes at some CpG sites of MEST and DLK differentially methylated regions in preeclamptic group PMID: 29157033
- Some growth-regulating imprinted genes such as MEST and MEG3, are susceptible to non-imprinted allele during development and differentiation, whereas the intergenic differentially methylated region of others (i.e. PEG3) are strictly maintained. PMID: 28854270
- strongly expressed in invasive extravillous trophoblasts during the first trimester PMID: 27697227
- G4 formation at motifs not previously identified through bioinformatic analysis of the MEST promoter, is reported. PMID: 28052120
- altered DNA methylation at imprinted domains including IGF2/H19 and PEG1/MEST may mediate the association between human papillomavirus infection and invasive cervical cancer PMID: 23775149
- The expression levels of miR-335 significantly correlated with those of MEST, supporting the notion that the intronic miR-335 is co-expressed with its host gene PMID: 23229728
- DNA methylation level at the H19 and MEST differentially methylated regions (DMRs)is reduced in placentas from pregnancies conceived by IVF/ICSI when compared with placentas from spontaneous conception. PMID: 23343754
- Paternal methylation aberrations at imprinting control regions of DLK1-GTL2, MEST (PEG1), and ZAC (PLAGL1) and global methylation levels are not associated with idiopathic recurrent spontaneous miscarriages. PMID: 23415968
- These results support the idea that intrauterine exposure to gestational diabetes mellitus has long-lasting effects on the epigenome of the offspring. PMID: 23209187
- MEST showed tissue-specific imprinting, being paternally expressed in skeletal muscle, fat, pituitary gland, heart, kidney, lung, stomach and uterus, and maternally expressed in spleen and liver. PMID: 22531794
- In cortices, the MEST promoter was hemimethylated, as expected for a differentially methylated imprinting control region, whereas the COPG2 and TSGA14 promoters were completely demethylated, typical for transcriptionally active non-imprinted genes. PMID: 22456293
- Regardless of conception method, the PEG1 methylation percentage in chorionic villus from spontaneous abortions is significantly higher than in villus from induced abortions and multifetal reduction. PMID: 21575949
- data demonstrated that tumorigenesis of leiomyoma is associated with overexpression of isoform 1 of PEG1/MEST gene, but not with loss of imprinting of the gene PMID: 20339302
- MEST gene is imprinted in an isoform-specific manner in adult lymphocytes. PMID: 10631159
- MEST gene is imprinted, with preferential expression from the paternal allele in fetal tissues. PMID: 9192843
- Findings suggest that PEG1/MEST can be excluded as a major determinant of Silver-Russell syndrome. PMID: 11754049
- An imprinted PEG1/MEST antisense expressed predominantly in human testis and in mature spermatozoa. PMID: 11821432
- Mutation screening and imprinting analysis of candidate genes for autism in the 7q32 region PMID: 11920156
- a novel mechanism /promoter switch/ leading to biallelic expression in invasive breast cancer PMID: 12023987
- An intron contains a sequence, MESTIT1, which is transcribed only from the paternal allele, may be involved in MEST regulation PMID: 12095916
- Lof imprinting of PEG1/MESTOI may be related to tumorigenesis and malignant transformation, especially in NSCLC PMID: 15547750
- PEG1 isoform 2 is in fact imprinted in a large subset of human placentae. PMID: 16338457
- Hypermethylation of paternally expressed genes including PEG1/MEST, which have growth-promoting effects, may be relevant to low birth weight in subjects conceived by assisted reproduction techniques. PMID: 17450433
- Type of epimutation at the PEG1/MEST locus does not play a relevant role in Silver-Russell syndrome. PMID: 18585117
- MEST is localized to the endoplasmic reticulum/Golgi apparatus where its putative enzymatic properties as a lipase or acyltransferase, predicted from sequence homology with members of the alpha/beta fold hydrolase superfamily. PMID: 18644838
顯示更多
收起更多
-
亞細(xì)胞定位:Endoplasmic reticulum membrane; Multi-pass membrane protein.
-
蛋白家族:AB hydrolase superfamily
-
組織特異性:Highly expressed in hydatidiform moles, but barely expressed in dermoid cysts. Biallelic expression is detected in blood lymphocytes. Seems to imprinted in an isoform-specific manner rather than in a tissue-specific manner in lymphocytes. Isoform 1 is exp
-
數(shù)據(jù)庫(kù)鏈接:
Most popular with customers
-
-
YWHAB Recombinant Monoclonal Antibody
Applications: ELISA, WB, IHC, IF, FC
Species Reactivity: Human, Mouse, Rat
-
Phospho-YAP1 (S127) Recombinant Monoclonal Antibody
Applications: ELISA, WB, IHC
Species Reactivity: Human
-
-
-
-
-